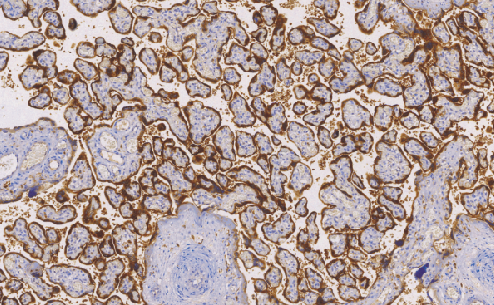
兔抗人绒毛膜促性腺激素(β)多克隆抗体

相关产品推荐更多 >
万千商家帮你免费找货
0 人在求购买到急需产品
- 详细信息
- 文献和实验
- 技术资料
- 形态:
Liquit
- 保存条件:
-20℃
- 克隆性:
多克隆
- 适应物种:
Human,(predicted:Mouse,Rat,)
- 保质期:
1年
- 抗原来源:
peptiede
- 目录编号:
TDCHR-0140
- 级别:
科研级
- 库存:
88
- 供应商:
武汉天德
- 宿主:
兔
- 浓度:
1mg/ml
- 抗体英文名:
Human CHorionic Gonadotrophin(Beta)
- 抗体名:
Human CHorionic Gonadotrophin(Beta)
- 规格:
1ml工作液
Human Chorionic Gonadotrophin(Beta)兔抗人绒毛膜促性腺激素(β)多克隆抗体
人绒毛膜促性腺激素(hCG)为糖蛋白激素,在受孕后10到12天胎盘滋养细胞开始产生hCG。在孕期的头三个月中胎儿需要hCG来维持,hCG结合到卵巢黄体中刺激孕激素产生,接下来由孕激素维持分泌期子宫内膜。HCG有a和B两个亚基组成,hCG的a亚基与黄体生长激素、甲状腺刺激激素和滤泡刺激激素的亚基相同。α共同链与激素特异性B链分子量分别为14kD和17kD,HCGB亚基是β含糖蛋白激素家族唯一在COOH末端包含29个氨基酸序列的亚基。目前认为,C末端区的HCG-B亚基对细胞内异二聚体的行为起作用。
- 货号:TDCHR-0140
- 克隆号:多克隆
- 阳性部位:胞质
- 适用组织:石蜡组织
- 预处理:热修复
风险提示:丁香通仅作为第三方平台,为商家信息发布提供平台空间。用户咨询产品时请注意保护个人信息及财产安全,合理判断,谨慎选购商品,商家和用户对交易行为负责。对于医疗器械类产品,请先查证核实企业经营资质和医疗器械产品注册证情况。
文献和实验该产品被引用文献
技术资料暂无技术资料 索取技术资料
文献支持
兔抗人绒毛膜促性腺激素(β)多克隆抗体
询价









